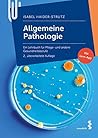

“Being proper and sweet and nice and pleasing is a fucking nightmare. It’s exhausting. As women, we get the message about how to be a good girl – how to be a good, pretty girl – from such an early age. Then, at the same time, we’re told that well-behaved girls won’t change the world or ever make a splash. So it’s sort of like, well, what the fuck am I supposed to be? I’m supposed to be a really polite revolutionary?” Phoebe Waller-Bridge spreads her arms and starts to laugh. “It’s impossible.”
―
―
entchowpee’s 2024 Year in Books
Take a look at entchowpee’s Year in Books, including some fun facts about their reading.
Favorite Genres
Polls voted on by entchowpee
Lists liked by entchowpee